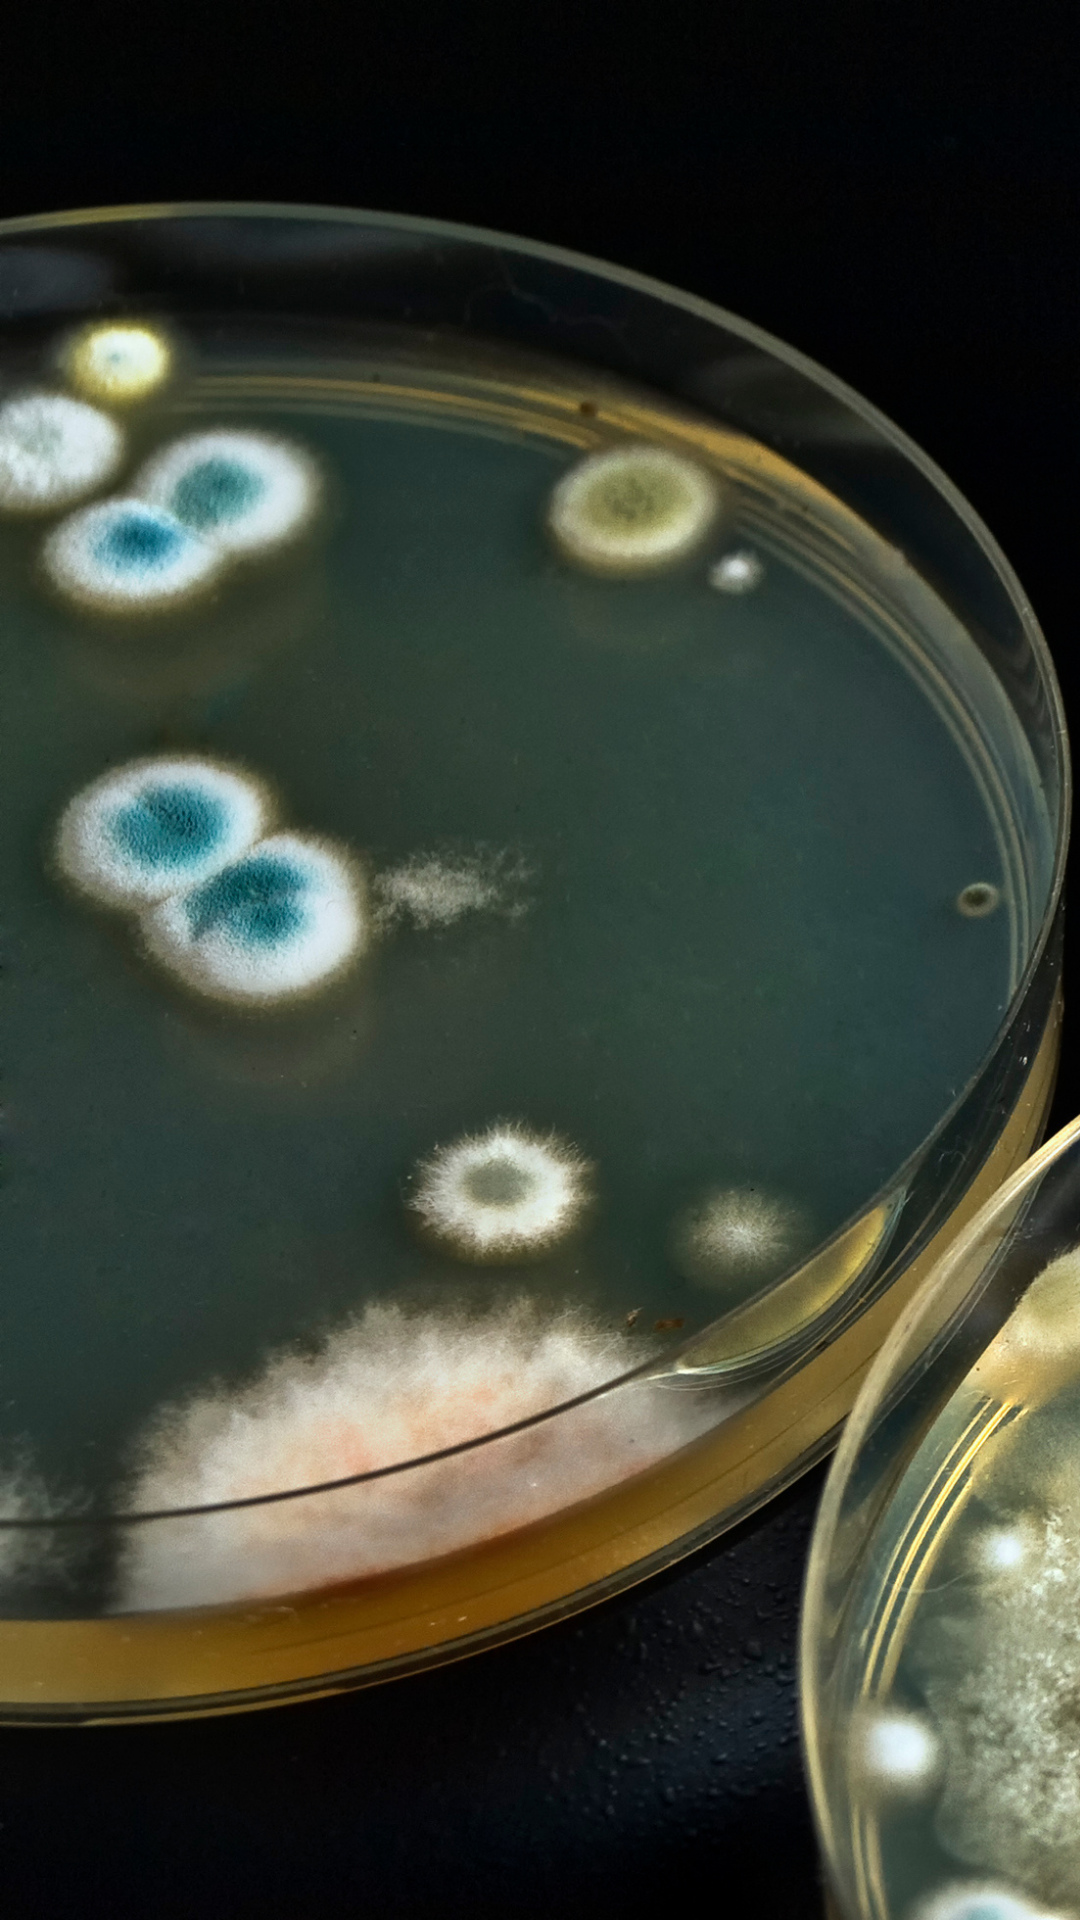

Hinweise

Desinfektionsmittel
Die Verwendung von Desinfektionsmitteln kann, wenn sie nicht ordnungsgemäß angewendet wird, potenzielle Gefahren für die Gesundheit und die Umwelt darstellen. Einige mögliche Gefahren sind: Hautreizungen und allergische Reaktionen: Desinfektionsmittel enthalten Chemikalien, die Hautreizungen und allergische Reaktionen hervorrufen können. Personen, die häufig Desinfektionsmittel verwenden, können ein erhöhtes Risiko haben, Hautprobleme zu entwickeln. Atemwegsreizungen: Einige Desinfektionsmittel können starke Gerüche und Dämpfe freisetzen, die die Atemwege reizen können. Dies kann insbesondere für Personen mit Atemwegserkrankungen wie Asthma gefährlich sein. Giftige Dämpfe: Einige Desinfektionsmittel können bei unsachgemäßer Verwendung giftige Dämpfe freisetzen, die beim Einatmen Gesundheitsprobleme verursachen können. Schädigung der Umwelt: Einige Desinfektionsmittel können schädlich für die Umwelt sein, insbesondere wenn sie in großen Mengen in die Abwässer gelangen. Einige Desinfektionsmittel können auch schädlich für die Tier- und Pflanzenwelt sein. Entwicklung von resistenzen: Wenn Desinfektionsmittel häufig und unsachgemäß angewendet werden, können sich Bakterien und Viren entwickeln, die gegen sie resistent sind. Dies kann dazu führen, dass Desinfektionsmittel im Laufe der Zeit weniger wirksam werden.Es ist daher wichtig, Desinfektionsmittel nur gemäß den Anweisungen des Herstellers zu verwenden und sie niemals in großen Mengen oder in der Nähe von Kindern oder Haustieren aufzubewahren.

Schnellkochtöpfe | Autoklaven
Beim Gebrauch von Schnellkochtöpfen und deren Umbau gibt es verschiedene Gefahren und Risiken, die man im Auge behalten sollte. Es wird dringend empfohlen, keine nicht EU-zertifizierten Schnellkochtöpfe zu verwenden, da diese möglicherweise nicht den erforderlichen Sicherheitsstandards entsprechen. Es ist wichtig zu verstehen, dass Schnellkochtöpfe nicht dafür vorgesehen sind, Pilzzuchtsubstrate zu sterilisieren. Es liegt in der Verantwortung jedes Benutzers, sich an die Anweisungen des Herstellers zu halten und bei Unsicherheiten professionelle Beratung einzuholen. Mögliche Konsequenzen, die aus der Nutzung von Schnellkochtöpfen resultieren, müssen von jedem selbst getragen werden. Es ist unerlässlich, bei der Verwendung von Schnellkochtöpfen sicher und vorsichtig zu sein, um Unfälle und Verletzungen zu vermeiden. Die Sicherheit sollte immer an erster Stelle stehen. Zusammenfassend sollten Schnellkochtöpfe mit größter Vorsicht behandelt werden und nicht umgebaut werden, da dies zu einer erheblichen Gefährdung der Sicherheit führen kann.

Pilzsporen
Die Risiken von Pilzsporen hängen von verschiedenen Faktoren ab, einschließlich der Art des Pilzes, der Menge an Sporen und der Empfindlichkeit des individuellen Organismus gegenüber Pilzsporen. In der Regel sind Pilzsporen in der Luft allgegenwärtig und stellen für gesunde Menschen keine Gefahr dar. Allerdings kann die Kultivierung von Pilzen zuhause das Risiko erhöhen, Pilzsporen einzuatmen, insbesondere wenn keine angemessene Belüftung vorhanden ist. Bei der Aufzucht von Pilzen in Innenräumen können die Sporen in die Luft gelangen und eingeatmet werden. Dies kann zu einer Reizung der Atemwege führen und in einigen Fällen sogar eine Lungeninfektion auslösen. Menschen mit geschwächtem Immunsystem, Asthma oder anderen Atemwegserkrankungen können besonders empfindlich auf Pilzsporen reagieren. Daher sollten diese Personen besonders vorsichtig sein, wenn sie Pilze zuhause anbauen. Es ist auch wichtig, Pilzsporen nicht direkt einzuatmen. Wenn möglich, sollten Pilzzüchter eine Atemschutzmaske tragen, um sich vor dem Einatmen von Sporen zu schützen.
Kontaminiertes Substrat
Es besteht eine allgemeine Erkenntnis, dass das Verzehren von Pilzen, die auf kontaminiertem Substrat gezüchtet wurden, ein Risiko für die Gesundheit darstellen kann. Pilze haben die Fähigkeit, Giftstoffe und Schwermetalle aus ihrer Umgebung aufzunehmen und in ihrem Gewebe zu speichern. Wenn sie auf einem kontaminierten Substrat wachsen, können sie Schadstoffe absorbieren, die sich darin befinden. Durch den Verzehr von Pilzen, die auf kontaminiertem Substrat gewachsen sind, können unterschiedliche gesundheitliche Probleme auftreten. Es kann zu einer Anreicherung von Toxinen und Schwermetallen im Körper kommen, die eine Vielzahl von Symptomen wie Übelkeit, Erbrechen, Durchfall, Kopfschmerzen und Schwindel hervorrufen können. In schweren Fällen kann es sogar zu Organversagen führen. Es sollte beachtet werden, dass Pilze, die auf kontaminiertem Substrat gezüchtet wurden, nicht immer offensichtlich erkennbar sind. Sie können genauso aussehen wie Pilze, die auf sauberem Substrat gezüchtet wurden. Wenn man Zweifel hat, ob die Pilze sicher sind, sollte man lieber auf den Verzehr verzichten.

UVC
Die Verwendung von UV-C Strahlung zur Sterilisation in der Pilzzucht birgt gewisse Gefahren, die die Gesundheit von Menschen gefährden können. Die hohe Intensität der UV-C Strahlung kann sowohl kurz- als auch langfristige Schäden an der Haut und Augen verursachen, wie beispielsweise Sonnenbrand, Hautalterung, Tränenbildung und Schädigung der Netzhaut. Darüber hinaus kann die unsachgemäße Verwendung von UV-C Strahlung auch zur Produktion von Ozon führen, einem schädlichen Gas, das bei Einatmen Gesundheitsschäden verursachen kann, wie beispielsweise Husten, Atemnot und Schädigung der Lungenfunktion. Es ist daher wichtig, dass bei der Verwendung von UV-C Strahlung in der Pilzzucht ausreichende Sicherheitsvorkehrungen getroffen werden, um die Gesundheit von Menschen zu schützen. Dazu gehört das Tragen von geeigneter Schutzkleidung und Schutzbrillen sowie die Kontrolle der Expositionsdauer und Intensität der UV-C Strahlung. Es ist auch wichtig, dass die Pilzzuchtanlagen ausreichend belüftet sind, um die Ansammlung von Ozon zu vermeiden.

Pilze sammeln
Beim Pilze sammeln ist Vorsicht geboten, da immer ein potenziell tödliches Risiko besteht. Es ist daher wichtig, nur Pilze zu sammeln, wenn man über das nötige Wissen und die Erfahrung verfügt. Die Bestimmung von Pilzen basiert auf individuellen Merkmalen und erfordert genaue Kenntnisse. Man sollte sich niemals auf allgemeine Regeln oder ähnliche Hinweise verlassen. Selbst bei als Speisepilze bekannten Arten können individuelle Unverträglichkeiten auftreten. Zudem können überreife Pilze eine "unechte Pilzvergiftung" verursachen, bei der unangenehme Symptome auftreten können. Daher ist es wichtig, Pilze anhand des tatsächlichen Objekts zu beurteilen, um festzustellen, ob sie noch gut und verzehrbar sind. Um sicherzustellen, dass ihr Pilze korrekt bestimmt und einschätzt, empfehle ich euch, euch an einen Pilzsachverständigen zu wenden. Diese Experten sind speziell ausgebildet und können euch bei der Identifizierung von Pilzen und der Beurteilung ihrer Verzehrbarkeit unterstützen. Auf der Webseite der Deutschen Gesellschaft für Mykologie (DGfM) findet ihr eine Liste von Pilzsachverständigen und weitere nützliche Informationen:
Deutschland Österreich Schweiz
Denkt immer daran, dass eure Gesundheit an erster Stelle steht und ihr kein Risiko eingehen solltet. Wenn ihr euch unsicher seid oder nicht über ausreichend Wissen verfügt, ist es ratsam, das Sammeln von Pilzen zu unterlassen oder Hilfe von einem Experten in Anspruch zu nehmen.

Zecken
Beim Pilzesammeln solltet ihr die Gefahr von Zeckenbissen nicht unterschätzen. Diese kleinen Blutsauger sind in Deutschland weit verbreitet und können gefährliche Krankheiten wie Borreliose und Frühsommer-Meningoenzephalitis (FSME) übertragen. Besonders in den südlichen FSME-Risikogebieten ist besondere Vorsicht geboten.
Warum Zecken ein Risiko darstellen
Zecken halten sich in hohen Gräsern, Sträuchern und Wäldern auf – genau dort, wo viele Pilze wachsen. Ein Zeckenbiss bleibt oft unbemerkt, kann aber schwerwiegende Folgen haben: Borreliose, verursacht durch Bakterien, kann Gelenk-, Herz- und Nervenschäden hervorrufen. FSME ist eine durch Viren verursachte Hirnhautentzündung, die zu schweren neurologischen Schäden führen kann.
Schutzmaßnahmen für Pilzsammler
Um das Risiko eines Zeckenbisses zu minimieren, beachtet bitte folgende Tipps:
Helle, lange Kleidung tragen: Helle Kleidung hilft, Zecken leichter zu erkennen. Tragt lange Hosen und geschlossene Schuhe, um den Zugang zur Haut zu erschweren. Steckt die Hosenbeine in die Socken, um zusätzlichen Schutz zu bieten.
Zeckenschutzmittel nutzen: Verwendet Insektenschutzmittel, die speziell gegen Zecken wirken. Achtet auf die Anwendungshinweise der Produkte.
Körper gründlich absuchen: Untersucht euren Körper so bald wie möglich nach jedem Aufenthalt im Wald sorgfältig auf Zecken. Es ist ratsam, dies direkt nach dem Sammeln zu tun, eventuell in Kombination mit einer Dusche. Achtet besonders auf warme und weiche Hautstellen wie Kniekehlen, Achseln, Hüftbereich und hinter den Ohren, da Zecken dort häufig zu finden sind. Diese Stellen sind besonders gefährdet, wenn Zecken durch Kleidung eindringen können, z.B. durch Reißverschlüsse, grobe Nähte oder Übergangsstellen zwischen Oberteil und Hose.
Zecken richtig entfernen: Wenn ihr eine Zecke entdeckt, entfernt sie umgehend mit einer Zeckenzange oder -karte. Stellt sicher, dass ihr die Zecke vollständig entfernt, um das Risiko einer Krankheitsübertragung zu minimieren. Vermeidet es, die Zecke mit den Fingern zu zerdrücken oder sie mit Öl zu ersticken.
Nützliche Links:
FSME-Risikogebiete in Deutschland
Zeckeninformationen und Ratgeber